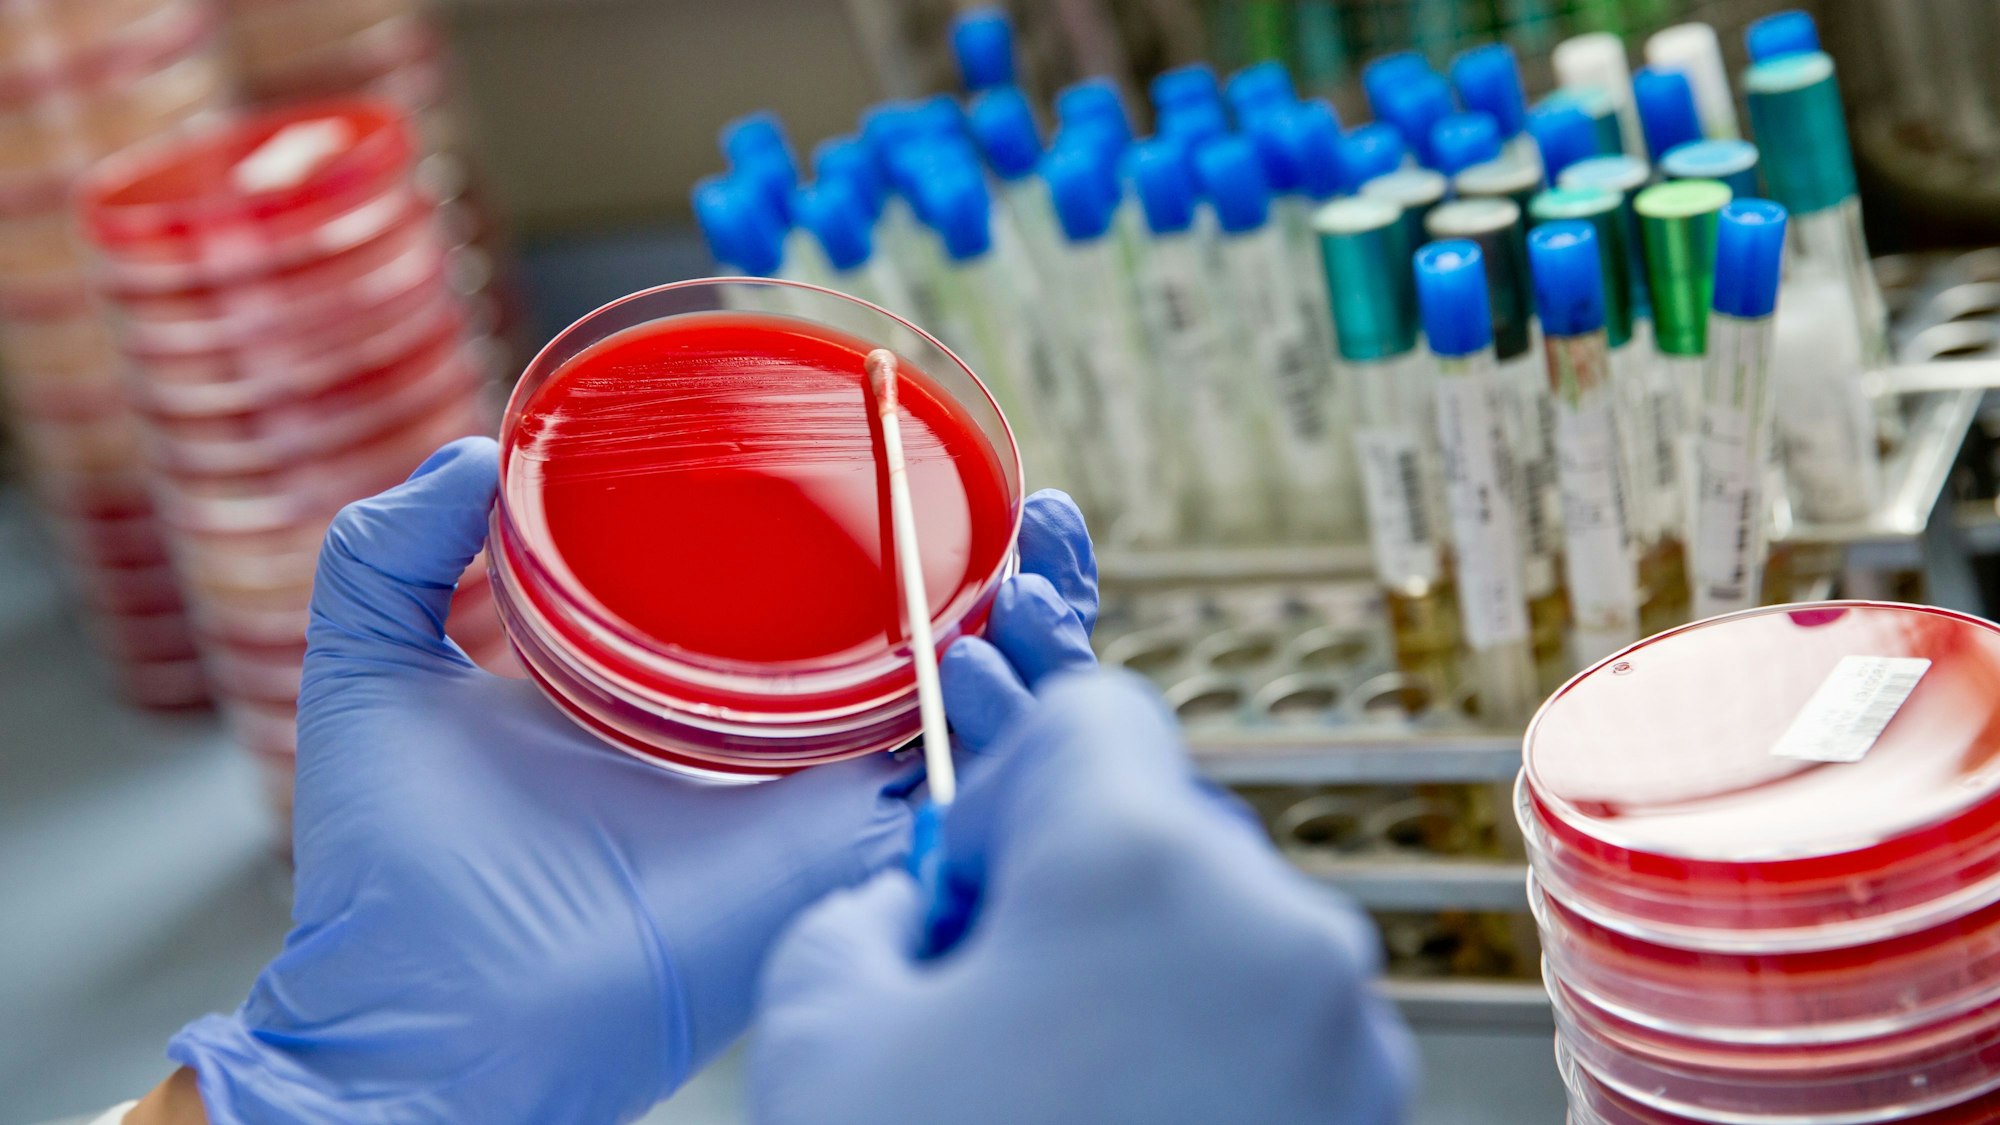

Bakterien sind nicht nur schädlich, sondern auch nützlich und sogar notwendig. Gilt das für Viren auch?
Dogmen in der MedizinBakterien können Freunde sein – Viren auch?
Könne auch Viren Freunde des Menschen sein? Eine bestimmte Art etwa scheint vor Hautkrebs zu schützen.
Copyright: picture alliance / Daniel Karmann/dpa
Die Wissenschaft der Medizin ändert sich langsam. Dogmen sind sehr resistent gegen Veränderungen: Sehr lange war es etwa unbestritten, dass Bakterien für den Menschen grundsätzlich gefährlich, potenziell tödlich sind. Bakterien wurden – und werden – mit Unmengen von Antibiotika bekämpft. Deren leichtfertige Verschreibung und Einnahme führen nicht selten zur Resistenzbildung. Und: Antibiotika verschieben das Verhältnis der unterschiedlichen Bakterienarten im Körper zueinander. Das ist insofern gefährlich, als dass es eben auch „gute“ Bakterienarten gibt. „Gut“ im Sinne von ungefährlich, oder auch im Sinne von überlebensnotwendig – für den Menschen!
Bakterien sind eben nicht nur Feinde, sondern auch Freunde – je nach Art und Ort. Im Darm etwa sind sie unverzichtbar für die Verdauung. Aber sie leben auch in der Mundhöhle oder auf der Haut. Es sind Billionen. Mehr noch: In und auf dem Menschen leben mehr Bakterien, als der Mensch selbst an Körperzellen hat. Würde man die Gesamtheit der Bakterien abtöten, würde der Mensch das nicht überleben. Weil Bakterien zahlreiche Funktionen im Körper haben, werden sie funktionell sogar mit einem menschlichen Organ verglichen.
Und nun ändert sich in der Medizin wieder eine Art Dogma: Auch Viren scheinen nicht nur „böse“ zu sein, sondern oft auch wichtig. Auch sie sind im Körper des Menschen in großer Zahl verbreitet, auch sie sind billionenfach vorhanden. Viren sind erstaunliche „Lebewesen“: Sie haben keinen eigenen Stoffwechsel (sind sie überhaupt „lebendig“?) und können sich nur vermehren, wenn sie ihr genetisches Programm in einen lebenden Organismus einschleusen – und er die Vermehrung für sie übernimmt. Und auch Viren scheinen nicht nur schädlich, sondern auch nützlich zu sein. Das Zusammenspiel zwischen Viren, Bakterien und Körperzellen ist offenbar sehr viel komplexer, als bisher gedacht.
Wie viele Viren gibt es überhaupt? Und wo sind sie?
Nun soll die Summe dieser Viren erstmals erfasst werden. Forscherinnen und Forscher von gleich fünf Universitäten wollen einen Überblick erstellen. Dazu werden Blut und Spucke, Stuhl, Milch und andere Proben untersucht. Die Ausbeute dürfte zahlreich sein: Schon ein Gramm Stuhl enthält Milliarden von Viren. Interessant dürfte neben der Vielfalt der Viren im Menschen auch deren Verteilung sein: Sind Viren grundsätzlich in allen Organen des Körpers oder gibt es „sterile“ Organe – etwa das Gehirn? Welche Virenarten sind wo? Spannend ist auch der Vergleich mehrerer Menschen: Haben wir alle dieselben Virentypen im Körper – oder unterscheiden sie sich? Haben Menschen, die zusammenleben, haben Familien dieselben Viren oder unterscheiden sie sich auch hier?
Schützen uns Viren, indem sie für uns gefährliche Bakterien abtöten? Oder „arbeiten“ sie mit denen irgendwie zusammen? Es gibt Hinweise, dass einzelne Viren für den Menschen nützlich sind: Eine bestimmte Virenart scheint etwa gegen Hautkrebs zu schützen. Und das dürfte nicht das einzige Beispiel bleiben. Viren zu verstehen heißt auch, die Gesundheit besser zu verstehen.